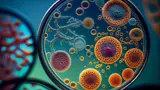

The curriculum of the first cycle of the Faculty of Education is a four-year study (240 ECTS) based on the Bologna Declaration. In accordance with the ECTS credit transfer system (European Credit Transfer System – ECTS), one academic year carries 60 ECTS, or one semester 30 ECTS credits. The number of study credits for a particular subject is determined according to the total student workload (theoretical and/or practical classes, exercises, seminars, etc.), the time spent by the student on independent tasks (homework, projects, seminar papers, etc.) and the time spent studying in preparation for knowledge assessment and assessment (tests, final exam, etc.).
The rules of study for the first cycle of studies at the University (www.unmo.ba) define and regulate in more detail the methods of organization and implementation of the first cycle of studies leading to an academic title and professional title of undergraduate study.
At the Faculty of Education, undergraduate studies are organized into eight departments:
- Biology
- Chemistry
- Pedagogy
- Classroom teaching
- Psychology and sociology
- Sports and health
- Professional study in the field of sports
- Preschool education
More detailed information about the first cycle of studies at individual departments can be found on the department's subpage.
Najnovije vijesti
Join us!
Become a student at the Faculty of Education
Become an inspiration to future generations